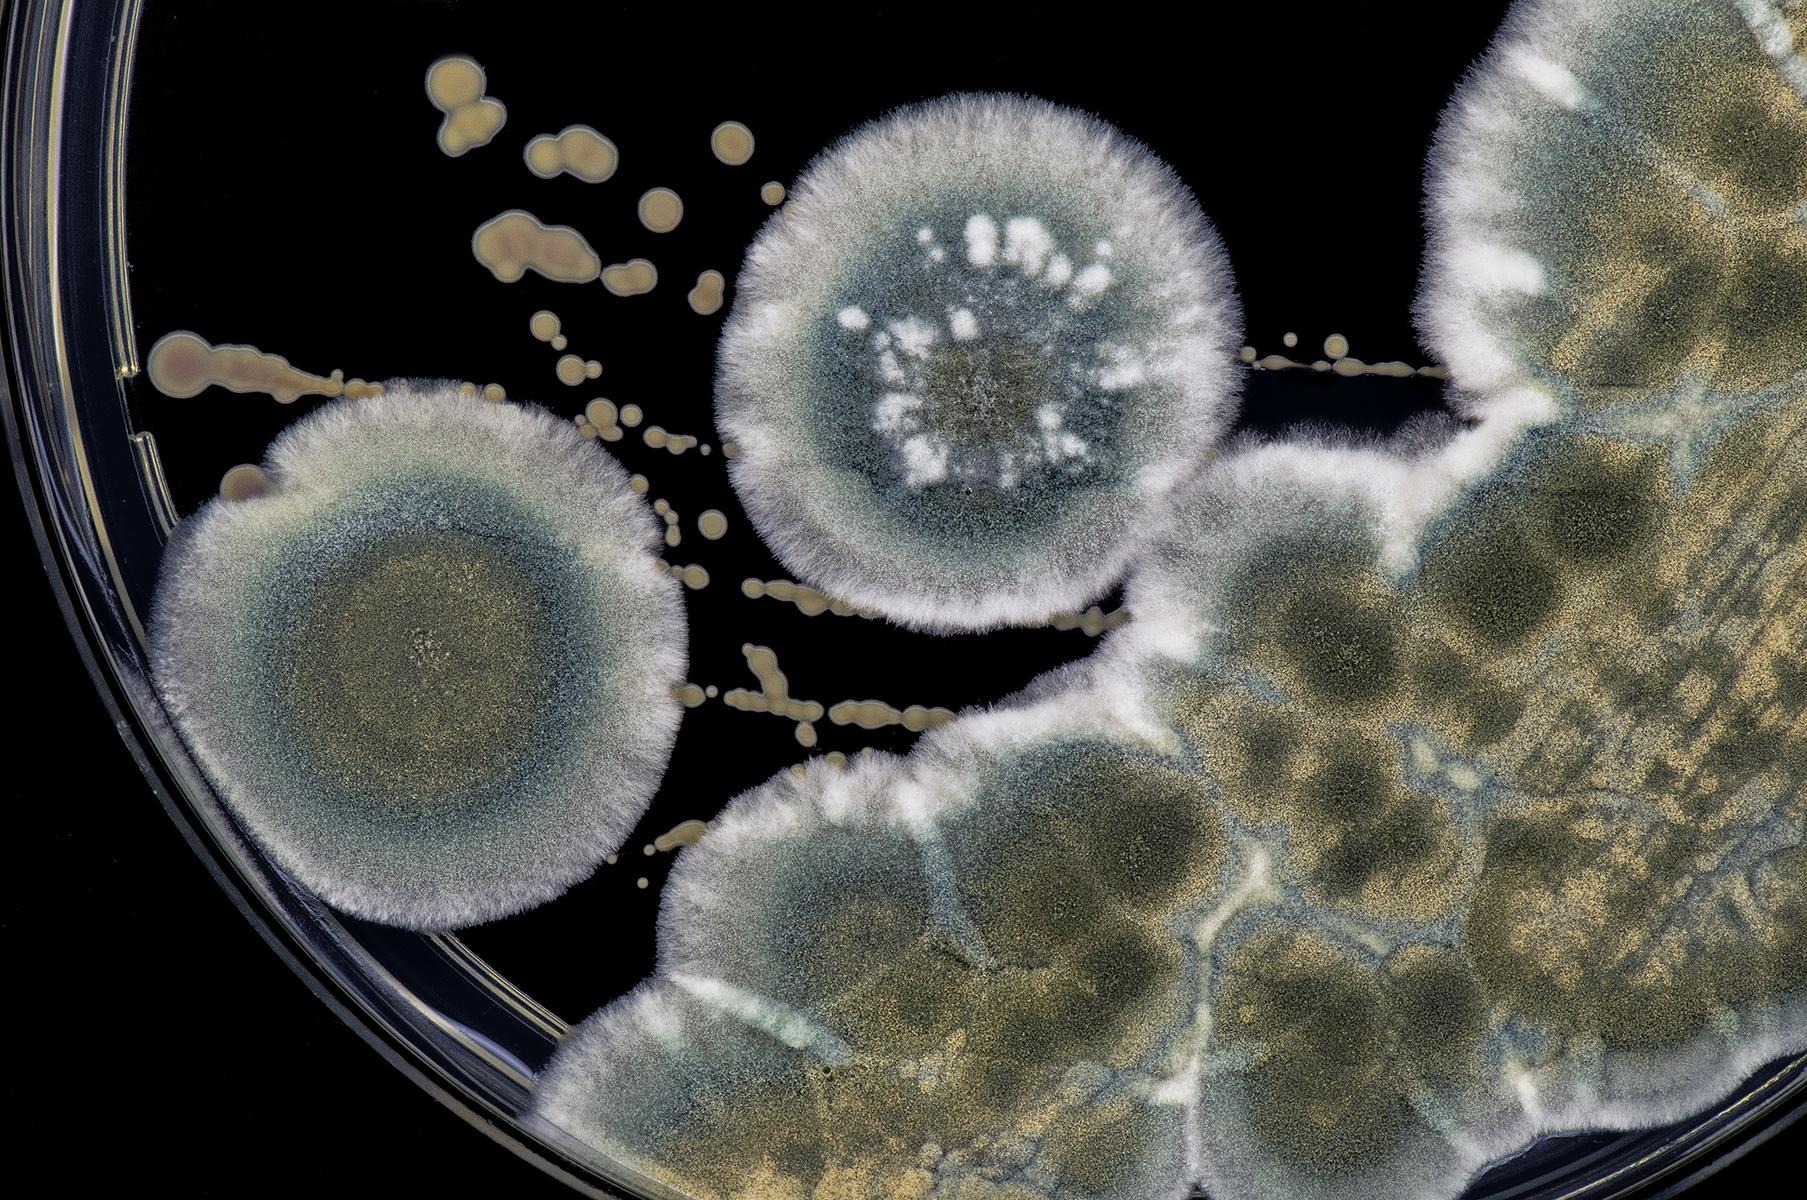

ОРВИ является распространенной патологией, которая передается воздушно-капельным путем и поражает верхние дыхательные пути. Основным возбудителем заболевания служит вирус, поэтому терапия осуществляется с применением противовирусных медикаментов и симптоматического лечения. Антибиотики при ОРВИ у детей назначаются при присоединении бактериальной инфекции либо развитии каких-либо опасных осложнений. Такие сильнодействующие лекарства должен подбирать только врач и от любого самостоятельного их приема лучше всего отказаться.
Симптоматика патологии
ОРВИ является острой респираторной инфекцией, которая преимущественно поражает дыхательные пути. ОРЗ – объединяет заболевания вирусной и бактерицидной этиологии, поражающие верхние и нижние дыхательные пути. У детей часто диагностируются такие сложные болезни, как воспаление легких, тонзиллит, грипп, парагрипп и бронхит.
На начальной стадии развития, симптоматика вирусных и бактериальных инфекций имеет много общего, поэтому часто специалисты ставят ребенку такой общий диагноз, как ОРЗ. В своем развитии патологии проходят инкубационный и продромальный период, и каждый из них сопровождается появлением характерных симптомов. При попадании вирусов в организм инкубационный период продолжается от нескольких часов до 4-5 суток, а при бактериальном инфицировании симптомы не проявляются до 14 дней.
Для ОРВИ характерно появление следующих симптомов:
- насморк в виде прозрачных и жидких выделений;
- температура выше 38, 5 градусов;
- раздражающий кашель, который через несколько суток переходит во влажный;
- сильный отек носоглотки;
- покраснение глаз и слезотечение;
- слабость и общее недомогание.
При ОРВИ у ребенка краснеет горло, но гнойный налет при этом отсутствует. При вирусном поражении организма уже через 4-5 суток ребенок начинает чувствовать облегчение. Это объясняется тем, что именно к этому сроку в организме скапливаются интерфероны, направленных на уничтожение инфекции. Максимальная концентрация белков-защитников вырабатывается на третьи сутки от начала патологии. В ситуации, когда спустя 3 дня состояние ребенка не улучшается, то врачи назначают прием антибактериальных средств. Это связано с тем, что, скорее всего, в организм попала бактериальная инфекция.
Врачи единодушны в том, что антибиотики не являются эффективным средством лечения ОРВИ у детей, так как эти заболевания вызываются вирусами, а не бактериями. Назначение антибиотиков в таких случаях может привести к развитию устойчивости бактерий и негативным последствиям для здоровья ребенка. Специалисты рекомендуют применять антибиотики только при наличии бактериальных осложнений, таких как пневмония или отит. Важно, чтобы лечение назначал квалифицированный врач, который сможет оценить состояние ребенка и определить необходимость применения антибиотиков. Родителям следует строго соблюдать рекомендации врача по дозировке и продолжительности курса, чтобы избежать побочных эффектов и сохранить эффективность препаратов. В большинстве случаев для облегчения симптомов ОРВИ достаточно симптоматической терапии, включая обильное питье, отдых и жаропонижающие средства.

Принципы назначения антибиотиков

Детям антибиотики при ОРВИ разрешается назначать лишь при бактериальных инфекциях, которые начинают развиваться как последствие простуды либо же спустя некоторое время после нее. Родителям необходимо понимать, что прием любого антибактериального средства является серьезным испытанием для организма, которое может сопровождаться нарушением функционирования кишечника, иммунной и пищеварительной системы. С учетом такой особенности прием антибиотиков назначается параллельно с поддерживающей терапией, что позволяет не допустить сбоев в работе организма.
Особую опасность антибиотики представляют при ОРВИ для детей до года. В таком возрасте прием таких сильнодействующих препаратов может усугубить еще не до конца сформировавшийся иммунитет ребенка, что нередко заканчивается развитием различных осложнений и проблем со здоровьем.
Многие родители ошибочно полагают, что при лечении у детей простуды антибактериальными препаратами, является единственным действенным методом лечения. На самом деле, к приему таких сильнодействующих препаратов прибегают в том случае, если традиционное лечение не помогло избежать развития осложнений.
Специалисты выделяют некоторые признаки, при появлении которых могут назначаться антибиотики ребенку при ОРВИ:
- слишком высокая температура тела, которая сопровождается образованием на гландах гнойного налета;
- болевые ощущения в ушах и снижение слуха;
- хрипы в легких и откашливание мокроты с примесью гноя или крови;
- появление признаков гнойного воспалительного процесса в носовых пазухах.
Антибактериальный препарат является лекарственным средством узкой направленности с сильным эффектом. Его необходимо принимать в строго назначенной дозировке, иначе состояние ребенка может еще больше ухудшиться по причине появления побочных эффектов. Именно по этой причине такие сильнодействующие лекарства должен назначать только специалист с учетом возраста ребенка и наличия у него тех или иных осложнений.
Правила приема антибиотиков
Для того, чтобы прием антибактериальных препаратов оказался эффективен в борьбе с ОРВИ, родителям необходимо соблюдать некоторые правила. Ни в коем случае не разрешается самостоятельно приобретать такое лекарство без назначения врача. Кроме этого, категорически запрещено менять назначенный антибиотик на препарат с таким же действующим веществом, если это не назначил врач.
Особое отношение у детских педиатров к тем детям, которые принимали антибиотики за последние 2-3 месяца. Об этом необходимо обязательно сообщить врачу, поскольку слишком велика опасность угнетения микрофлоры кишечника.
Во время антибактериальной терапии необходимо обязательно давать ребенку препараты, действие которых направлено на профилактику дисбактериоза. Для этой цели можно использовать бифидобактерии и лекарства, которые воздействуют непосредственно на микрофлору кишечника. Пить такие средства рекомендует на протяжении всего лечения антибиотиками. Спустя несколько дней после начала приема антибактериальных средств состояние ребенка может заметно улучшиться, а все неприятные симптомы исчезают. Несмотря на это, необходимо до конца пропить полный курс антибиотиков, иначе слишком велика опасность того, что болезнь не будет долечена.
При проведении антибактериальной терапии такие сильнодействующие вещества должны сохраняться в организме ребенка в течение 7-10 суток, поэтому лучше не пропускать приемы лекарства. Кроме этого, принимать антибиотик необходимо в одно и то же время и в строго назначенной дозировке.
Не разрешается прерывать курс лечения детскими антибиотиками и заменять препарат на другой, поскольку это может закончиться развитием осложнений либо переходом болезни из острой формы в хроническую. Для восстановления работы иммунной системы параллельно с антибактериальным лечением рекомендуется принимать витаминные комплексы. Это позволит ускорить выздоровление и наполнить организм полезными веществами.
Применять антибиотики для лечения ОРВИ разрешается лишь при условии, что без их использования состояние ребенка еще больше ухудшиться. Подбор таких сильнодействующих препаратов должен осуществлять специалист с учетом возбудителя, который спровоцировал болезнь.
Антибиотики часто вызывают споры среди родителей, когда речь идет о лечении ОРВИ у детей. Многие считают, что эти препараты необходимы для борьбы с вирусами, однако врачи подчеркивают, что антибиотики эффективны только против бактериальных инфекций. При ОРВИ, вызванном вирусами, их назначение нецелесообразно и может привести к развитию устойчивости бактерий. Родители должны помнить, что основными методами лечения являются поддерживающая терапия, обильное питье и отдых. Если у ребенка наблюдаются осложнения или признаки бактериальной инфекции, врач может рассмотреть возможность назначения антибиотиков. Важно следовать рекомендациям специалиста и не заниматься самолечением, чтобы избежать негативных последствий для здоровья ребенка.

Антибиотики про ОРВИ
Антибактериальные препараты при ОРВИ назначаются при бактериальной инфекции, и для ее подтверждения проводится специальное исследование мазка из гортани и носа. Какие антибиотики можно принимать при ОРВИ и ОРЗ в детском возрасте? При ОРВИ разрешается применять практически все препараты, которые назначаются при иных проявлениях жизнедеятельности бактерий. При этом важно учитывать возраст ребенка и специфику локализации возбудителей.
При борьбе с заболеванием могут назначаться антибактериальные препараты следующих групп:
- Лекарства пенициллинового ряда. Такие препараты отличаются широким спектром действия на организм, быстро всасываются и эффективны в борьбе с инфекциями различных групп. Однако, у бактерий достаточно быстро вырабатывается устойчивость к активному веществу антибиотиков пенициллинового ряда.
- Цефалоспорины. Медикаменты такой группы выделяются низкой степенью токсичности и эффективны даже в ситуациях, когда антибиотики пенициллинового ряда становятся бессильными.
- Аминогликозиды. Такие антибактериальные препараты назначаются детям лишь в том случае, если ОРВИ вызывает развитие тяжелых осложнений.
- Макролиды. Антибиотики такой группы оказывают угнетающее воздействие на различных бактерий и обладают широким спектром действия.
Необоснованный прием антибактериальных препаратов становится причиной дисбактериоза и аллергических реакций. Такие сильнодействующие медикаменты уничтожают не только вредные микроорганизмы, но и полезные бактерии.
Группа пенициллинов
Антибиотики пенициллинового ряда являются медикаментами первого поколения и применяются при диагностике у ребенка тонзиллита или бактериальной ангины. Пенициллин оказывает на детский организм широкий спектр действия, и быстро выводится мочой. С учетом такой особенности он может уничтожить инфекцию, которая локализуется в почках. При лечении ОРВИ специалисты отдают предпочтение полусинтетическим пенициллинам и наиболее популярными средствами считаются:
- Аугментин;
- Флемоклав;
- Амоксиклав;
- Оспамокс.
Основным недостатком антибактериальных препаратов такой группы считаются высокий риск развития побочных эффектов. У детей при лечении с их помощью может появляться сыпь на теле, раздражение кожи и отечность тканей. Многие бактерии отличаются хорошей устойчивостью к пенициллинам, поэтому врачи часто назначают медикамент в сочетании с клавулановой кислотой. Она помогает блокировать свойство бактерии разрушать антибиотик.

Макролиды
Антибиотики группы макролидов являются наиболее эффективными лекарственными препаратами, которые назначаются при осложнениях вирусного характера. Их разрешается применять при терапии детей после 6 месяцев, поскольку они наносят организму минимальный токсический вред. Группу со сложной структурой составляют медикаменты на основе следующих антибиотиков:
- Мидекамицин;
- Кларитромицин;
- Эритромицин;
- Азитромицин;
- Джозамицин.
Прием макролидов может сопровождаться развитием таких побочных эффектов, как снижение аппетита, болевые ощущения в животе, рвота и тошнота. Преимущественно при лечении детей назначают такие антибактериальные препараты, как Азимед, Клацид, Сумамед, Макропен и Хемомицин.
Антибиотики-цефалоспорины
При запущенных ОРВИ и инфекциях бактерицидного характера в стационарных условиях назначают пить антибактериальные препараты цефалоспоринового ряда.
Наиболее распространенными представителями такой группы считаются следующие медикаменты:
- Зинацеф;
- Панцеф;
- Супракс;
- Зиннат.
Антибиотики такой группы отличаются агрессивным воздействием на кишечную микрофлору, поэтому их прием часто сопровождается появлением диареи, сыпи и тошноты. Внутривенное введение медикаментов в организм существенно понижает опасность различных нарушений со стороны пищеварительной системы. При лечении детей до 12 лет принимать антибиотики можно лишь в суспензии. Запрещено самостоятельно назначать такие антибиотики, поскольку основным их предназначением считается уничтожение серьезных патогенных бактерий в детском организме. Не разрешается применять такие препараты при нарушении работы почек у детей, а к инъекционному введению прибегают лишь в крайних случаях.
Обзор антибиотиков при ОРВИ
В том случае, если к вирусной инфекции или простуде присоединилась бактериальная, то лечение обычно проводится с использованием антибиотиков. Чаще всего для устранения такого заболевания назначаются следующие лекарственные препараты:
- Амоксиклав является комбинированным полусинтетическим пенициллиновым антибиотиком, который можно начинать давать детям с 3 месяцев. Такой препарат выпускается в форме сухого порошка для приготовления суспензии, таблеток, сухого вещества для разведения инъекции и порошка для приготовления пероральных капель. Дозировку антибиотика рассчитывает только специалист с учетом возраста ребенка и сложности заболевания.
- Экоклав – это антибиотик пенициллинового ряда, который выпускается в форме таблеток и сухого вещества для приготовления суспензии в домашних условиях. Дозировка лекарства зависит от степени тяжести патологии, а дети весом более 40 кг могут принимать взрослую дозу антибиотика.
- Сумамед является антибиотиком широкого спектра действия, и относится к группе макролидов-азалидов. При пероральном приеме препарат проникает внутрь клеточной инфекции и оказывает разрушающее действие. Антибиотик назначается на 3-5 дней и если ребенку становится лучше, его прием прекращают.
- Макропен относится к группе макролидов и выпускается в форме таблеток и гранул, которые используются для приготовления суспензии. Таблетки назначаются детям старше 3 лет, а принимать суспензию необходимо в зависимости от веса ребенка.
- Амоксициллин эффективен в устранении стрептококков, стафилококков и грамотрицательных возбудителей. Комплексная терапия с использованием такого препарата должна проводиться не менее 5 дней, причем запрещено прерывать лечение спустя несколько суток после начала приема. При осложненной форме заболевания продолжительность приема Амоксициллина может составлять до 2 недель.
- Флемоксин солютаб является антибиотиком широкого спектра действия, в составе которого присутствует пенициллин. Выпускается такое медикаментозное средство в виде таблеток и обладает выраженным бактерицидным действием. Кроме этого, такой антибиотик эффективен в уничтожении бактерий кишечной палочки, стафилококков и хламидий. В организме Флемоксин солютаб разлагается в печени и выводится вместе с мочой. Прием лекарства противопоказан пациентам, которые страдают язвой желудка и дисбактериозом, а также тем, кто имеет индивидуальную непереносимость к пенициллину. Разрешается прием антибиотика во время беременности и грудного вскармливания, но лишь при наличии серьезных показаний.
Назначение антибиотиков для детей при ОРВИ проводится лишь в ситуациях, когда к патологии присоединилась инфекция бактериального характера. Принимать такие лекарственные препараты необходимо лишь под контролем врача и строго соблюдать назначенную дозировку.
Вопрос-ответ
Почему антибиотики неэффективны при ОРВИ?
Антибиотики предназначены для борьбы с бактериальными инфекциями, тогда как ОРВИ вызываются вирусами. Вирусы и бактерии имеют разные механизмы действия, и антибиотики не способны уничтожать вирусы, поэтому их применение при ОРВИ нецелесообразно.
Когда следует рассмотреть возможность назначения антибиотиков ребенку с ОРВИ?
Антибиотики могут быть назначены, если у ребенка развиваются бактериальные осложнения, такие как пневмония или синусит, после первоначального вирусного заболевания. Важно, чтобы решение о назначении антибиотиков принимал врач на основе клинической картины и результатов обследования.
Какие меры можно предпринять для облегчения симптомов ОРВИ у детей?
Для облегчения симптомов ОРВИ у детей рекомендуется обеспечить достаточное количество жидкости, использовать жаропонижающие средства при высокой температуре, а также применять увлажнители воздуха для облегчения дыхания. Важно также следить за режимом отдыха и питания ребенка.
Советы
СОВЕТ №1
Не назначайте антибиотики самостоятельно. При ОРВИ антибиотики неэффективны, так как это вирусные инфекции. Обратитесь к врачу для получения правильного диагноза и рекомендаций по лечению.
СОВЕТ №2
Следите за симптомами. Если у ребенка наблюдаются высокие температуры, сильный кашель или другие серьезные симптомы, обязательно проконсультируйтесь с врачом, чтобы исключить бактериальные инфекции, которые могут требовать антибиотикотерапии.
СОВЕТ №3
Соблюдайте режим приема антибиотиков. Если врач все же назначил антибиотики, строго следуйте его указаниям по дозировке и времени приема, чтобы избежать развития устойчивости бактерий к лекарствам.
СОВЕТ №4
Обратите внимание на побочные эффекты. При приеме антибиотиков у детей могут возникать побочные реакции, такие как расстройства пищеварения или аллергические реакции. В случае их появления немедленно обратитесь к врачу.








